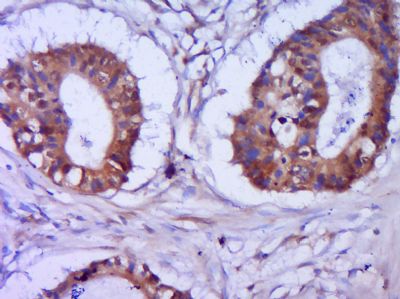
产品封面图

相关产品推荐更多 >
万千商家帮你免费找货
0 人在求购买到急需产品
- 详细信息
- 文献和实验
- 技术资料
- 供应商:
上海康朗生物科技有限公司
- 库存:
大量
- 目录编号:
kl-5239R
- 克隆性:
多克隆
- 抗原来源:
Rabbit
- 保质期:
12个月
- 抗体英文名:
phospho-CDKN1A/p21 (Ser146) antibody
- 抗体名:
磷酸化p21蛋白抗体
- 宿主:
Rabbit
- 适应物种:
Human, Dog, Pig, Cow, Sheep, Guinea Pig, G
- 免疫原:
KLH conjugated Synthesised phosphopeptide derived from human CDKN1A around the phosphorylation site of Ser146 [QT(p-S)MT]:QT(p-S)MT
- 亚型:
IgG
- 形态:
冻干粉或液体
- 应用范围:
ELISA=1:500-1000 IHC-P=1:400-800 IHC-F=1:400-800 IF=1:100-500
- 浓度:
1mg/ml
- 保存条件:
-20 °C
- 规格:
100ul
| 中文名称 | 磷酸化p21蛋白抗体 |
| 别 名 | CDKN1A/p21 (phospho Ser146); CDKN1A/p21 (phospho S146); p21 (phospho Ser146); Activating Fragment 1; CAP20; Cation chloride cotransporter-interacting protein 1; CDK Interacting Protein 1; CDK-interacting protein 1; CDKI; CDKN 1; CDKN1; CDKN1A; CIP1; Cyclin Dependent Kinase Inhibitor 1A; Cyclin-dependent kinase inhibitor 1; Cyclin-dependent kinase inhibitor 1A (P21); Cyclin-dependent kinase inhibitor 1A (p21, Cip1); DNA Synthesis Inhibitor; MDA 6; MDA-6; MDA6; Melanoma Differentiation Associated Protein 6; Melanoma differentiation-associated protein 6; Melanoma differentiation-associated protein; p21; P21 protein; p21CIP1; p21WAF; PIC1; SDI1; SLC12A9; WAF1; Wildtype p53 Activating Fragment 1; Wildtype p53-activated fragment 1; CDN1A_HUMAN. |
| 规格价格 | 100ul/1580元 购买 大包装/询价 |
| 说 明 书 | 100ul |
| 产品类型 | 磷酸化抗体 |
| 研究领域 | 肿瘤 免疫学 信号转导 |
| 抗体来源 | Rabbit |
| 克隆类型 | Polyclonal |
| 交叉反应 | Human, Dog, Pig, Cow, Sheep, Guinea Pig, G |
| 产品应用 | ELISA=1:500-1000 IHC-P=1:400-800 IHC-F=1:400-800 IF=1:100-500 (石蜡切片需做抗原修复) not yet tested in other applications. optimal dilutions/concentrations should be determined by the end user. |
| 分 子 量 | 18kDa |
| 细胞定位 | 细胞核 细胞浆 |
| 性 状 | Lyophilized or Liquid |
| 浓 度 | 1mg/ml |
| 免 疫 原 | KLH conjugated Synthesised phosphopeptide derived from human CDKN1A around the phosphorylation site of Ser146 [QT(p-S)MT]:QT(p-S)MT |
| 亚 型 | IgG |
| 纯化方法 | affinity purified by Protein A |
| 储 存 液 | 0.01M TBS(pH7.4) with 1% BSA, 0.03% Proclin300 and 50% Glycerol. |
| 保存条件 | Store at -20 °C for one year. Avoid repeated freeze/thaw cycles. The lyophilized antibody is stable at room temperature for at least one month and for greater than a year when kept at -20°C. When reconstituted in sterile pH 7.4 0.01M PBS or diluent of antibody the antibody is stable for at least two weeks at 2-4 °C. |
| PubMed | PubMed |
| 产品介绍 | background: This gene encodes a potent cyclin-dependent kinase inhibitor. The encoded protein binds to and inhibits the activity of cyclin-CDK2 or -CDK4 complexes, and thus functions as a regulator of cell cycle progression at G1. The expression of this gene is tightly controlled by the tumor suppressor protein p53, through which this protein mediates the p53-dependent cell cycle G1 phase arrest in response to a variety of stress stimuli. This protein can interact with proliferating cell nuclear antigen (PCNA), a DNA polymerase accessory factor, and plays a regulatory role in S phase DNA replication and DNA damage repair. This protein was reported to be specifically cleaved by CASP3-like caspases, which thus leads to a dramatic activation of CDK2, and may be instrumental in the execution of apoptosis following caspase activation. Two alternatively spliced variants, which encode an identical protein, have been reported. Two families of cyclin dependent kinase inhibitors (CKIs) have been identified. The p21WAF1/Cip1 family inhibits all kinases involved in the G1/S transition. The p16INK4a family inhibits Cdk4 and Cdk6 specifically. Function: May be the important intermediate by which p53/TP53 mediates its role as an inhibitor of cellular proliferation in response to DNA damage. Binds to and inhibits cyclin-dependent kinase activity, preventing phosphorylation of critical cyclin-dependent kinase substrates and blocking cell cycle progression. Functions in the nuclear localization and assembly of cyclin D-CDK4 complex and promotes its kinase activity towards RB1. At higher stoichiometric ratios, inhibits the kinase activity of the cyclin D-CDK4 complex. Subunit: Interacts with HDAC1; the interaction is prevented by competitive binding of C10orf90/FATS to HDAC1 facilitating acetylation and protein stabilization of CDKN1A/p21. Interacts with MKRN1. Interacts with PSMA3. Interacts with PCNA. Component of the ternary complex, cyclin D-CDK4-CDKN1A. Interacts (via its N-terminal domain) with CDK4; the interaction promotes the assembly of the cyclin D-CDK4 complex, its nuclear translocation and promotes the cyclin D-dependent enzyme activity of CDK4. Binding to CDK2 leads to CDK2/cyclin E inactivation at the G1-S phase DNA damage checkpoint, thereby arresting cells at the G1-S transition during DNA repair. Interacts with PIM1. Subcellular Location: Cytoplasm. Nucleus. Post-translational modifications: Phosphorylation of Thr-145 by Akt or of Ser-146 by PKC impairs binding to PCNA. Phosphorylation at Ser-114 by GSK3-beta enhances ubiquitination by the DCX(DTL) complex. Phosphorylation of Thr-145 by PIM2 enhances CDKN1A stability and inhibits cell proliferation. Phosphorylation of Thr-145 by PIM1 results in the relocation of CDKN1A to the cytoplasm and enhanced CDKN1A protein stability. Ubiquitinated by MKRN1; leading to polyubiquitination and 26S proteasome-dependent degradation. Ubiquitinated by the DCX(DTL) complex, also named CRL4(CDT2) complex, leading to its degradation during S phase or following UV irradiation. Ubiquitination by the DCX(DTL) complex is essential to control replication licensing and is PCNA-dependent: interacts with PCNA via its PIP-box, while the presence of the containing the 'K+4' motif in the PIP box, recruit the DCX(DTL) complex, leading to its degradation. Acetylation leads to protein stability. Acetylated in vitro on Lys-141, Lys-154, Lys-161 and Lys-163. Deacetylation by HDAC1 is prevented by competitive binding of C10orf90/FATS to HDAC1. Similarity: Belongs to the CDI family. SWISS: P38936 Gene ID: 1026 Database links: Entrez Gene: 1026 Human Entrez Gene: 12575 Mouse Entrez Gene: 114851 Rat Omim: 116899 Human SwissProt: P38936 Human SwissProt: P39689 Mouse Unigene: 370771 Human Unigene: 195663 Mouse Unigene: 10089 Rat Important Note: This product as supplied is intended for research use only, not for use in human, therapeutic or diagnostic applications. p21蛋白的过度表达与肿瘤的类型、恶性度、分期以及病人的预后密切相关。主要用于胃肠道癌肿、乳腺癌、肺癌等恶性肿瘤的研究。 |
| 产品图片 |
Paraformaldehyde-fixed, paraffin embedded (Human cervical cancer); Antigen retrieval by boiling in sodium citrate buffer (pH6.0) for 15min; Block endogenous peroxidase by 3% hydrogen peroxide for 20 minutes; Blocking buffer (normal goat serum) at 37°C for 30min; Antibody incubation with (p-CDKN1A (Ser146)) Polyclonal Antibody, Unconjugated (bs-5239R) at 1:400 overnight at 4°C, followed by operating according to SP Kit(Rabbit) (sp-0023) instructionsand DAB staining.
|
风险提示:丁香通仅作为第三方平台,为商家信息发布提供平台空间。用户咨询产品时请注意保护个人信息及财产安全,合理判断,谨慎选购商品,商家和用户对交易行为负责。对于医疗器械类产品,请先查证核实企业经营资质和医疗器械产品注册证情况。
文献和实验人可溶性CD146分子(sCD146)ELISA试剂盒 说明书
人可溶性CD146 分子 ( sCD146 )ELISA 试剂盒 ( 用于血清、血浆、细胞培养上清液和其它生物体液内 ) 原理 本实验采用双抗体夹心 ABC-ELISA 法。用抗人 sCD146 单抗包被于酶标板上,标准品和样品中的 sCD146与单抗结合,加入生物素化的抗人 sCD146 ,形成免疫复合物连接在板上,辣根过氧化物酶标记的 Streptavidin 与生物素结合,加入底物工作液显蓝色,最后
下调不能说明活性降低,因为决定GSK3-beta的活性的还与其磷酸化的比例和磷酸化的位点有关。所以你除了要做GSK3-beta总的蛋白表达之外,还要做磷酸化的GSK3-beta的蛋白表达。 (2)应该活性形式和非活性形式都做。一般来讲,GSK3-beta在Ser9位点磷酸化之后活性收到抑制,而在216位点磷酸化之后,其活性收到加强。因此建议将GSK3-beta的两个磷酸化位点都做了,另外还要同时检测GSK3-beta的总蛋白表达,这样才能全面的说明问题。
双特异抗体(Bispecific antibody)的简介和制作方法
contain two identical antigen-binding arms and a constant fragment, (Fc)g. The Fc part enables the antibody to function as an adaptor protein, linking antibody-bound cells to immune cells bearing Fcg receptors. Because there are different Fcg receptors
技术资料暂无技术资料 索取技术资料